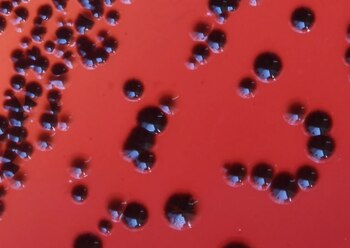
La bacteria P. gingivalis, responsable

El mal de Alzheimer es uno de los mayores misterios de la medicina. Y mientras los investigadores tratan de encontrar sus causas, esta enfermedad neurodegenerativa, por ahora sin cura, constituye la quinta causa de muerte en el mundo, ya que a medida que la población vive más años, su incidencia aumenta. Entre las nuevas hipótesis, un estudio publicó una idea alarmante: puede que el Alzheimer sea una infección.
Si bien la perspectiva no es novedosa, sí lo es la pista concreta que ofrece hacia un tipo de bacteria específica: Porphyromonas gingivalis, un cocobacilo Gram-negativo que causa la periodontitis crónica, o gingivitis.
El microbiólogo Jan Potempa, de la Universidad de Louisville, dirigió un equipo que halló esa bacteria en los cerebros de pacientes que murieron de Alzheimer. Y para comprobar la relación entre ella y la enfermedad, hicieron experimentos en ratones en los cuales hallaron que las infecciones bucales con ese bacilo aumentaron la producción de beta-amiloide, la proteína comúnmente asociada con el Alzheimer.

En la investigación participó Stephen Dominy, cofundador de la startup Cortexyme. La firma farmacéutica realiza estudios clínicos de una droga que podría impedir la proliferación de las toxinas de la P. gingivilis. Según su eficacia, se podría crear un tratamiento, y hasta una vacuna, contra la bacteria; lo cual no es equivalente a una vacuna contra el Alzheimer, pero abriría un camino importante para la investigación de terapias.
"Ya antes se han vinculado los agentes infecciosos al desarrollo y la progresión del Alzheimer, pero la evidencia de causalidad no ha sido convincente", dijo Dominy a Science Alert. "Ahora, por primera vez, tenemos pruebas sólidas que conectan al patógeno intracelular, el bacilo gram-negativo P. gigivalis, y el origen patológico del Alzheimer".
Además, el equipo halló en el cerebro de los pacientes muertos por esa enfermedad las enzimas tóxicas que secreta la bacteria, llamadas gingipaínas, en correlación con dos marcadores independientes del mal, la proteína tau y el marcador de proteínas ubicuitina.

Al examinar cerebros de personas que no sufrieron Alzheimer antes de su muerte, los científicos encontraron menores niveles de P. gingivalis, lo cual podría ser una señal de alerta: en caso de haber vivido más, podrían haber desarrollado la enfermedad.
"La identificación de gingipaínas en el cerebro de los individuos diagnosticados con Alzheimer, y también con la patología aunque no fueran diagnosticados, sugiere que la infección cerebral con P. gingivalis no es un resultado de mal cuidado de la salud dental debido al comienzo de la demencia, ni una consecuencia de las etapas finales de la enfermedad, sino una manifestación temprana", escribieron en el trabajo.
El estudio también puso a prueba la droga que desarrolla Cortexyme, llamada COR388, que actualmente está en ensayos clínicos con pacientes de Alzheimer. Al utilizarla en ratones, mostró su capacidad de reducir la cantidad de bacterias en una infección cerebral de P. gingivalis, a la vez que redujo la producción de beta-amiloides y la inflamación del tejido.
Sin embargo, "las drogas contra las proteínas tóxicas de la bacteria sólo han mostrado beneficios en ratones, hasta el momento", señaló David Reynolds, director científico de Alzheimer's Research. "Pero dado que hace más de 15 años que no hay un nuevo tratamiento para la demencia, es importante que probemos tantos enfoques como sea posible para detener enfermedades como el Alzheimer".
El mal suele distinguirse por la acumulación de proteínas amiloides y tau en el cerebro, que proliferan y se pueden asentar durante 10 o hasta 20 años antes de que se noten síntomas. Y si bien es posible tener placas amiloides sin sufrir demencia, los científicos han intentado controlarlas en la búsqueda de un tratamiento. Se estima que estas proteínas son una defensa contra las bacterias, lo cual abriría un nuevo camino a su control: eliminar el microorganismo que las provoca.
La P. gingivalis no sólo causa gingivitis: también se ha comprobado que es un factor de riesgo para enfermedades sistémicas inflamatorias, infecciones pulmonares, el infarto de miocardio, la arteriosclerosis y la anticipación del parto.

MÁS SOBRE ESTE TEMA:
Últimas Noticias
Un delincuente amenazó y gatilló a un hombre frente a su hijo en La Pampa: “Esto es para vos”
La víctima se encontraba en su auto cuando un motociclista se acercó y sacó un arma. La Policía lo detuvo en una vivienda, donde encontró más de 10 plantas de marihuana

Embalses de agua: la reserva subió este miércoles 18 de marzo
La reserva de agua en el país subió en un 0,53 % a comparación de la semana pasada, de acuerdo con Ministerio para la Transición Ecológica y el Reto Demográfico

La razón por la que no deberías reutilizar los vasos de las velas, según la química
Algunos usos dados a estos utensilios tras gastarse las velas pueden convertirse en prácticas potencialmente perjudiciales para la salud

Ampay completo: Mario Irivarren, Said Palao, Patricio Parodi y ‘Frencho’ protagonizan desenfrenada juerga en yate en Argentina
El viaje a Argentina estuvo marcado por celebraciones, amigos solteros y casados, alcohol y la presencia constante de jóvenes acompañantes



